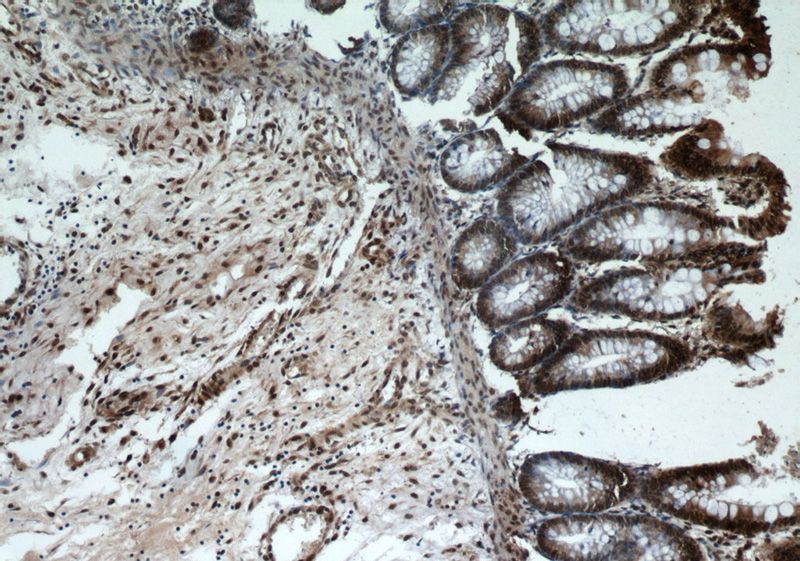
Immunohistochemical of paraffin-embedded human colon using Catalog No:115521(SP1 antibody) at dilution of 1:50 (under 10x lens)

-
Product Name
SP1 antibody
- Documents
-
Description
SP1 Rabbit Polyclonal antibody. Positive IP detected in A431 cells. Positive WB detected in Jurkat cells, A431 cells, HEK-293 cells, K-562 cells. Positive IF detected in HeLa cells. Positive IHC detected in human colon tissue, human stomach cancer tissue. Observed molecular weight by Western-blot: 95-106 kDa
-
Tested applications
ELISA, WB, IP, IHC, IF
-
Species reactivity
Human,Mouse,Rat; other species not tested.
-
Alternative names
SP1 antibody; Sp1 transcription factor antibody; Transcription factor Sp1 antibody; TSFP1 antibody
-
Isotype
Rabbit IgG
-
Preparation
This antibody was obtained by immunization of SP1 recombinant protein (Accession Number: NM_138473). Purification method: Antigen affinity purified.
-
Clonality
Polyclonal
-
Formulation
PBS with 0.02% sodium azide and 50% glycerol pH 7.3.
-
Storage instructions
Store at -20℃. DO NOT ALIQUOT
-
Applications
Recommended Dilution:
WB: 1:500-1:5000
IP: 1:200-1:2000
IHC: 1:20-1:200
IF: 1:20-1:200
-
Validations

Jurkat cells were subjected to SDS PAGE followed by western blot with Catalog No:115521(SP1 antibody) at dilution of 1:500

IP Result of anti-SP1 (IP:Catalog No:115521, 6ug; Detection:Catalog No:115521 1:500) with A431 cells lysate 2500ug.
Immunohistochemical of paraffin-embedded human colon using Catalog No:115521(SP1 antibody) at dilution of 1:50 (under 10x lens)

Immunohistochemical of paraffin-embedded human colon using Catalog No:115521(SP1 antibody) at dilution of 1:50 (under 40x lens)

Immunofluorescent analysis of HeLa cells using Catalog No:115521(SP1 Antibody) at dilution of 1:50 and Alexa Fluor 488-congugated AffiniPure Goat Anti-Rabbit IgG(H+L)
-
Background
The transcription factor Sp1 is a C2H2 zinc-finger protein that is involved in the regulation of a wide variety of genes, including housekeeping genes and tumor-developing genes. It is associated with tumor development, growth, and metastasis [PMID: 16209919]. It regulates the expression of a large number of genes involved in a variety of processes such as cell growth, apoptosis, differentiation and immune responses. Besides, it has a role in modulating the cellular response to DNA damage, recruiting SMARCA4/BRG1 on the c-FOS promoter, regulation of FE65 gene expression [PMID:11371615,16332679]. SP1 has some isoforms with MW ~95-106 kDa and ~60 kDa [PMID:17462816].
-
References
- Hsu TI, Wang MC, Chen SY. Betulinic acid decreases specificity protein 1 (Sp1) level via increasing the sumoylation of sp1 to inhibit lung cancer growth. Molecular pharmacology. 82(6):1115-28. 2012.
- Chen C, Xiang H, Peng YL, Peng J, Jiang SW. Mature miR-183, negatively regulated by transcription factor GATA3, promotes 3T3-L1 adipogenesis through inhibition of the canonical Wnt/β-catenin signaling pathway by targeting LRP6. Cellular signalling. 26(6):1155-65. 2014.
- Wen Y, Li J, Wang L. UDP-glucose dehydrogenase modulates proteoglycan synthesis in articular chondrocytes: its possible involvement and regulation in osteoarthritis. Arthritis research & therapy. 16(6):484. 2014.
- Yan L, Yu J, Tan F. SP1-mediated microRNA-520d-5p suppresses tumor growth and metastasis in colorectal cancer by targeting CTHRC1. American journal of cancer research. 5(4):1447-59. 2015.
- Aziz F, Wang X, Liu J, Yan Q. Ginsenoside Rg3 induces FUT4-mediated apoptosis in H. pylori CagA-treated gastric cancer cells by regulating SP1 and HSF1 expressions. Toxicology in vitro : an international journal published in association with BIBRA. 31:158-66. 2016.
- Chuang TD, Khorram O. Mechanisms underlying aberrant expression of miR-29c in uterine leiomyoma. Fertility and sterility. 105(1):236-245.e1. 2016.
Related Products / Services
Please note: All products are "FOR RESEARCH USE ONLY AND ARE NOT INTENDED FOR DIAGNOSTIC OR THERAPEUTIC USE"
